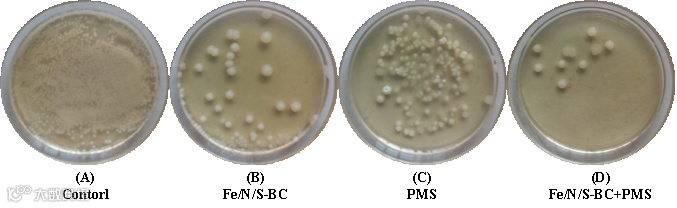

第一作者:杨小炳副教授、曾湘楚博士
通讯作者:曾湘楚 博士、冀豪栋 研究员、程科军 研究员
其他作者:陈晗纯、辛磊 高级实验师、潘俊杰 工程师
合作单位:武夷学院、河池学院、北京大学深圳研究生院、丽水市农林科学研究院、浙江中医药大学
文献信息:Xiaobing Yang, Xiangchu Zeng, Hanchun Chen, Lei Xin, Junjie Pan, Haodong Ji, Kejun Cheng. Coupled homogeneous/hetrogeneous Fenton-like system to enhance the synchronized decontamination of aqueous tetracycline and Salmonella typhi. Chemical Engineering Journal, 2024, 483, 148697.
https://doi.org/10.1016/j.cej.2024.148697
摘要
含重金属、抗生素和耐药细菌(ARB)的水体化学-生物协同污染对生态环境造成了诸多危害。本文提出了一种创新的降解—失活机制和一种耦合均相/非均相类Fenton体系,以协同净化水体四环素(TC)和耐TC伤寒沙门氏菌(TRST)。研究结果表明:在均相Cu(II)/PMS体系中,共存的微量Cu(II)与TC形成的铜配合物活化过氧一硫酸盐(PMS)可有效降解TC,并通过Cu(III)氧化使TRST失活。然而,由于Cu(III)转化产生的自由基有限,在单一Cu(II)/PMS体系中TRST的失活率仅为47%左右。在Cu(II)-TC-TRST三元污染物中加入Fe/N/S共掺杂的生物炭(Fe/N/S-BC)后,非均相Fe/N/S-BC/PMS体系与均相Cu(II)/PMS体系的耦合作用,产生丰富的活性氧(ROS),促进了TC的降解和TRST的失活。尽管存在Cu(II)和TC的竞争,均相/非均相耦合的类Fenton体系使TRST的失活率提高到98%以上。自由基(•OH、•O2-等)和非自由基(Cu(III)和1O2)途径均参与了Cu(II)-TC-TRST三元污染物中TC和TRST及其耐药基因(ARGs)的协同净化。
全文速读
基于水体多物质共污染问题,前期研究中发现水体重金属离子和偶氮染料的络合现象,并通过磁性复合材料的吸附、催化降解以及吸附—催化降解耦合,实现污染物的协同净化(Chemical Engineering Journal, 2023, 468, 143536;Chemosphere, 2023, 318, 137869;Journal of the Taiwan Institute of Chemical Engineers, 2023, 145, 104775;Journal of Environmental Management, 2023, 325, 116621;Journal of Environmental Management, 2022, 314, 114979)。
在前期研究的基础上,本实验以FeCl3·6H2O为磁性前驱体,甘蔗渣纤维为炭源,尿素、硫脲和硫酸铵为掺杂剂,采用浸渍-热解法合成了Fe-BC、Fe/N-BC、Fe/S-BC和Fe/N/S-BC等一系列杂原子掺杂的生物炭。通过以下四部分内容研究Cu(II)-TC-TRST三元污染物的协同净化性能与机制:1,通过Cu(II)/PMS体系探索了水体铜配合物的可能构型及其对TC的均相自催化降解作用;2,研究Fe/N/S-BC/PMS体系对TC的非均相催化降解性能及机理;3,通过耦合Cu(II)/PMS和Fe/N/S-BC/PMS体系揭示Cu(II)-TC-TRST三元污染物中TRST的失活性能及机理;4,在养殖废水处理中的实际应用。
1,Cu(II)-TC二元溶液中的络合行为及多尺度分子模型
图1(A)可知,由于铜配合物的生成,在TC溶液中加入Cu(II),UV-Vis吸光度强度随Cu(II)的加入而降低,并呈现0:10>10:10>5:10>10:5>10:0([Cu(II)]:[TC])的趋势。图1(B)中,在30 ℃下静置24 h后,得到一种棕色溶液,被认为是Cu(II)-TC配合物,看起来与原始溶液完全不同,在80 ℃高温下结晶沉淀2 h,在Cu(II)-TC二元溶液中生成铜配合物。图2对比络合前后溶液的质谱证明铜配合物的生成。图3提出水溶液中Cu(II)与TC的络合反应式及铜配合物可能的分子结构。图4为Cu(H2O)2+、TC、其络合物的分子模型及基于IGMH和IRI计算得到的络合物形成的作用机制,其作用力主要包括:范德华力、显著的弱相互吸引、共价键作用及空间位阻等。

图1 Cu(II)-TC二元体系(A)的紫外-可见吸光光谱及铜配合物的生成(B)

图2 TC单一溶液和Cu(II)-TC二元溶液的质谱分析。(A)正离子、(B)负离子
图3 水溶液中Cu(II)与TC的络合反应及铜络合物的分子结构

图4 铜络合物的演化和构型(A)、IGMH(B)和IRI(C)
2,磁性生物炭的制备与表征
以甘蔗渣纤维为炭源,FeCl3·6H2O为磁性前驱体,尿素、硫脲和硫酸铵为掺杂剂,采用“浸渍-热解”法在800 ℃氮气气氛下的管式炉中制备磁性生物炭(MBCs),并对其进行全面的结构表征(图5)。

图5 浸渍-热解法制备MBCs的流程图(A),Fe/N/S-BC的TEM(B、C)、HR-TEM(D)、SEM(E)以及EDS能谱面扫(F),MBCs的FT-IR(G)、XRD(H)、XPS全谱(I)、Raman(J),Fe/N/S-BC中S2p的XPS精细谱(K)及可能的缺陷和共掺杂结构(L)
3,催化降解性能与机理
3.1 降解性能
分别在溶液中加入0、5、10、20和30 mg的PMS,研究Cu(II)/PMS体系的均相自催化降解性能;在溶液中分别添加5、10、20、30 mg的Fe/N/S-BC和5 mg的PMS,研究Fe/N/S-BC/PMS的非均相活化催化降解效果,以及均相和非均相类Fenton体系TOC变化、降解动力学(图6)。当MPMS = 5 mg、Fe/N/S-BC为催化剂、反应时间为30 min时,降解效率最高达94.58%。

图6 紫外可见光谱(A-B),TOC含量(C),降解动力学(D、E)和拟一级模型拟合(F)
3.2 均相Cu(II)/PMS体系降解机理
Cu(II)-TC二元体系中存在不饱和铜配合物能够分解PMS,其中,Cu(II)和TC中含N、O基团之间发生氧化还原反应生成不饱和Cu(I)-TC配合物,这一起始步骤在铜配合物中Cu2p的高分辨率XPS光谱中得到进一步证实;其次,Cu(I)与TC之间的络合键伸展可以加速电子转移,促进PMS与Cu(I)的反应,并通过双电子转移生成Cu(III)配合物;最后,不稳定的铜配合物被进一步分解,通过分子内电子转移(IET)生成Cu(II)和TC自由基(•TC),并进一步降解为中间体,最终氧化生成CO2、H2O、NH4+和副产物。由此可见,Cu(III)而非自由基在Cu(II)/PMS类Fenton体系中对TC的降解起主要作用(图7)。


图7 通过DMPO和TEMP自旋捕获的•OH、•SO4-、•O2-和1O2的EPR信号(A),MeOH、t-BuOH、CHCl3和FFA对TC降解效率的影响(B),Cu(II)浓度对Cu(III)生成的影响(C),Cu(II)/PMS和Cu(II)/TC/PMS体系中Cu(III)的消耗动力学(D),均相Cu(II)/PMS体系中TC催化降解机理
3.3 非均相Fe/N/S-BC/PMS体系降解机理
非均相Fe/N/S-BC/PMS体系的强化降解机制主要来源于Fe/N/S-BC中Fe(Fe(II)/Fe(III))循环的加速、含氧基团(C-O、C=O、Fe-O)促进了电子的转移以及杂原子(N、S)的掺杂提高了炭基催化剂的石墨化程度,图8。

图8 新鲜和反应后Fe/N/S-BC中Fe2p(A)、O1s(B)、SP2-C和SP3-C(C)的含量,Fe-BC、Fe/N-BC、Fe/S-BC和Fe/N/S-BC中O、N、S的含量及石墨化程度(D),非均相Fe/N/S-BC/PMS体系的强化降解机制(E)
为了阐明S和N如何调节催化剂的电子结构,通过自旋极化功能计算揭示电荷密度差(图9)。其中,Fe/N/S-BC的N3-Fe-Fe-S3模型中,除了Fe-N和Fe-S中的电子密度增加外,Fe原子中心和配位原子中心的电子密度也增加,这将极大地促进电子从Fe、N、S原子向PMS的转移,增强其催化活性和反应动力学,但两个铁原子的中间和外围区域的电子密度下降。

图9 通过自旋极化泛函计算Fe-BC(A、E)、Fe/N-BC(B、F)、Fe/S-BC(C、G)及Fe/N/S-BC(D、H)的电荷差密度
3.4 降解路径及中间产物的毒理学
TC通过生成Cu(III)和ROS氧化引起的脱烷基、去羟基、脱酰胺、去甲基化、脱水、脱羰和开环等一系列反应降解,其中•SO4-、•OH和•O2-更容易攻击TC中的C-H、C-N、C=C和-NH2,而1O2更有选择性地吸引苯胺环和氨基结构,并且绝大部分中间产物具有更低的毒性(图10)。


图10 提出的TC降解路径及其副产物(A),中间产物的毒理学评价(B)
4,Cu(II)-TC-TRST三元体系中TRST的失活性能及机理
均相Cu(II)/PMS和非均相Fe/N/S-BC/PMS的耦合作用大大提高了耐药细菌TRST的失活效率(图11、14)。均相Cu(II)/PMS体系和非均相Fe/N/S-BC/PMS体系产生的Cu(III)和ROS(•OH、•SO4-、•O2-和1O2)协同作用使伤寒沙门氏菌细胞深度破坏和破裂(图12)。同时,耐药细菌的胞外物质(EOM)和胞内物质(IOM)几乎被Fe/N/S-BC/PMS体系生成的Cu(III)和ROS降解,进一步阐明了Cu(II)/PMS的均相自催化和Fe/N/S-BC/PMS的非均相活化催化协同作用增强了氧化能力(图13)。由于产生的Cu(III)和ROS与e-ARGs反应,约97.2%的e-tetA基因、99.2%的blemTEM-1基因和97.7%的mphA基因被降解(图15)。

图11 TRST在单一(A)和三元(B)溶液中的失活效率、水质影响(C)和细菌再生曲线(D)

图12 未处理(A-1、A-5、B-1、B-5)及经Fe/N/S-BC(A-2、A-6、B-2、B-6)、PMS(A-3、A-7、B-3、B-7)和Fe/N/S-BC/PMS处理(A-4、A-8、B-4、B-8)的伤寒沙门氏菌的SEM(A)和TEM(B)图像

图13 未处理(A-1、B-1)及经Fe/N/S-BC(A-2、B-2)、PMS(A-3、B-3)和Fe/N/S-BC/PMS处理(A-4、B-4)的伤寒沙门氏菌的三维荧光(A)和原子力显微镜(B)图像
图14 对照组及Fe/N/S-BC、PMS、Fe/N/S-BC+PMS处理后的TRST计数图像。(Cu(II)-TC-TRST三元污染物)

图15 包括TRST中tetA、blaTEM-1和mphA基因的细胞外抗生素耐药基因(e-ARGs)的降解效率
5,实际水体应用效果
处理180min后,对养殖废水中TC的降解和失活率达到98%。养殖废水TOC分别降低了68%和62%,对TC和TRST的降解和失活效率分别保持在93.8%和91.6%(图16)。

图16 猪场(A)和鸭场(B)养殖废水中TC和TRST的降解和失活动力学(V = 20 mL、MFe/N/S-BC = 10 mg、PMS = 5 mg),处理前后猪鸭养殖废水TOC含量(V = 20 mL、MFe/N/S-BC = 10 mg、PMS = 5 mg)(C), 5个循环后Fe/N/S-BC的催化稳定性(D)
结 论
水或废水中固有的痕量Cu(II)激活了PMS,并通过均相Cu(II)/PMS体系对TC和TRST进行了有效的降解和灭活。结果表明,Cu(III)而不是传统的ROS(•OH,•SO4-,•O2-和1O2)在降解和失活中起主导作用。为了增强Cu(II)-TC-TRST三元污染物中TC和TRST的协同净化效果,制备了一系列磁性生物炭(Fe-BC、Fe/N-BC、Fe/S-BC和Fe/N/S-BC),其中Fe/N/S-BC通过活化PMS产生自由基和非自由基,对TC表现出最佳的降解性能。Fe/N/S-BC催化PMS的高活性来源为:Fe、N、S的共掺杂加速了Fe物质(Fe(II)/Fe(III))的循环、促进了含氧基团(C-O、C=O、Fe-O)的电子转移、增强了杂原子(N和S)的石墨化程度。在Cu(II)-TC-TRST三元溶液中加入Fe/N/S-BC/PMS后,均相Cu(II)/PMS与非均相Fe/N/S-BC形成的耦合体系,通过Cu(III)与ROS的协同作用,将TC降解率和TRST失活率提高到98%以上。在本研究中,提出了一种创新的“降解-失活”方法和一种均相和非均相的类芬顿耦合体系,以协同去除水中包括化学和生物污染的三元污染体系。均相Cu(II)/PMS和非均相Fe/N/S-BC耦合体系对Cu(II)-TC-TRST的三元污染物具有良好的净化性能,可用于养殖废水的处理。
作者介绍
杨小炳:厦门大学博士,浙江大学/丽水市农林科学研究院博士后,武夷学院副教授,福州大学硕士研究生导师,福建省高层次C类人才,福建省高校杰青人才,迄今以第一作者在Nano-Micro Letters、Chemical Engineering Journal、Inorganic Chemistry Frontiers、International Journal of Hydrogen Energy、Arabian Journal of Chemistry等国内外SCI期刊上发表论文23篇,担任Nano-Micro Letters、Chemical Engineering Journal、International Journal of Hydrogen Energy、Journal of Photochemistry & Photobiology等SCI期刊审稿人。主要从事环境污染修复、中药材有毒物质处理、能源催化等方向的研究。
曾湘楚:博士(后)、讲师。迄今以第一、通讯作者在Chemical Engineering Journal、Chemosphere、Journal of Environmental Management、Journal of the Taiwan Institute of Chemical Engineers、化工进展、精细化工等国内外SCI、EI期刊上发表论文20篇,授权专利3项,主持项目6项。研究方向为:环境修复与能源催化材料、中药药效成分提取及毒害成分检测去除、量子化学计算。通讯邮箱:xiangchuzeng@163.com。
冀豪栋:北京大学深圳研究生院,Tenure-track助理教授/研究员/博士生导师/院长助理,长期从事环境量子化学污染修复技术开发和应用,迄今发表论文70余篇,入选IWA-YWP新星计划,担任Colloids and Surface C客座编辑,SCI期刊CCL和ESE青年编委。
程科军:博士,研究员。复旦大学药学学士、药物化学博士,美国埃默里大学博士后。国家重大农业人才计划入选者(首届,2022),浙江省有突出贡献中青年专家。现任丽水市农林科学研究院中药材所所长,国家级博士后科研工作站负责人。兼任中国民族医药协会理事,中国植物学会民族植物学分会理事,浙江省植物生理与植物分子生物学学会理事,浙江省药学会中药与天然药物专委会委员,浙江省中药材产业技术创新与推广服务团队专家,浙江省青年科学技术协会理事、农业科学委员会秘书长。主要从事道地中药资源评价与功效成分高效利用研究,主持国家自然科学基金、浙江省“尖兵”“领雁”研发攻关计划、浙江省农业新品种选育重大专项、农业农村部优势特色产业集群项目等项目12项,在Trends in Food Science&Technology、Chemical Engineering Journal、The Plant Journal、Food Chemistry、Food Research International等期刊发表论文80余篇,授权发明专利10项,主编专著4部,以第一完成人获浙江省科技进步奖三等奖2项(2017,2020)以及中国民族医药协会科学技术奖一等奖、中国商业联合会科学技术奖一等奖等国家级社会力量奖4项。获全国“杰出青年农业科学家”、全国青年岗位能手、浙江省五一劳动奖章、浙江省农业科技先进工作者、浙江省优秀科技特派员等荣誉。

点击分享 让更多人看到

微信扫一扫
关注该公众号


